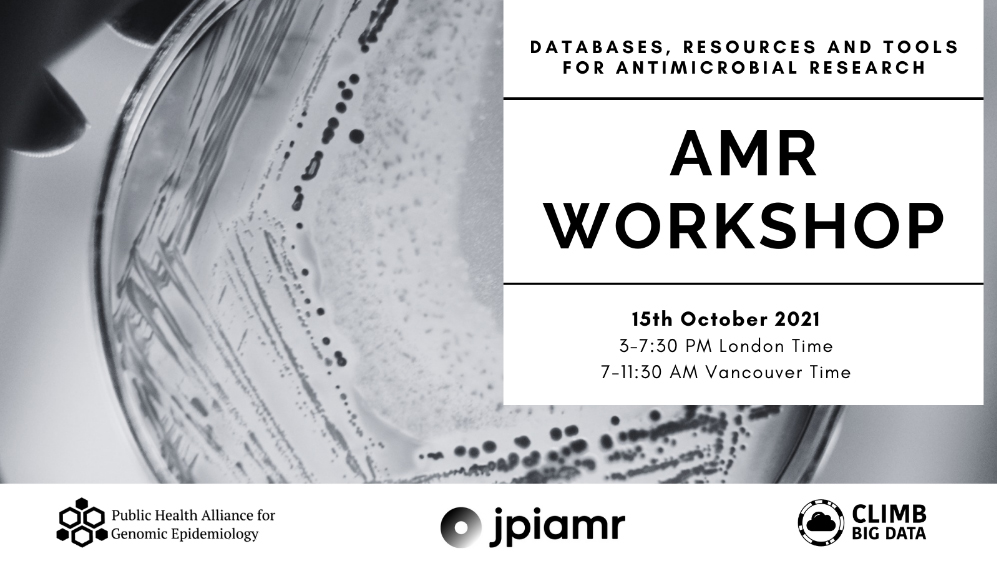

Workshop
Workshop on Antimicrobial Resistance (AMR)
Date: 15 October 2021
Format: Online training workshop
The Workshop on Antimicrobial Resistance (AMR) was delivered by the Public Health Alliance for Genomic Epidemiology (PHA4GE) in collaboration with CLIMB-BIG-DATA and the Joint Programming Initiative on Antimicrobial Resistance (JPIAMR).
This academic-focused workshop addressed the growing global threat of antimicrobial resistance by providing practical training in AMR genomics, bioinformatics tools, and standardised reporting approaches. The session brought together international experts to support researchers working with microbial genomic data in public health and research settings.
Workshop Focus and Learning Objectives
Antimicrobial resistance represents a major challenge to global health systems. This workshop was designed to support researchers and practitioners by introducing reproducible, standardised, and scalable approaches to AMR genomic analysis.
Participants were guided through:
- AMR databases and reference resources
Practical use of established AMR-related databases, including CARD, NCBI, and PATRIC, to support resistance gene identification and interpretation. - Bioinformatics tools for AMR gene detection
Theory and applied use of tools such as AMRFinderPlus for identifying antimicrobial resistance genes from whole genome sequencing data. - Standardised comparison and reporting of AMR results
Introduction to hAMRonization for harmonising outputs from different AMR detection tools and enabling consistent reporting. - End-to-end AMR genomics workflows
A practical overview of bioinformatics workflows that take sequencing reads through to interpretable AMR reports.
Organising Committee
Andrew Page
Quadram Institute, UK (CLIMB-BD, PHA4GE)
Emma Griffiths
Simon Fraser University, Canada (PHA4GE)
Mark Pallen
Quadram Institute, UK (CLIMB-BD)
Lisa Marchioretto
Quadram Institute, UK (CLIMB-BD)
Finlay Maguire
Dalhousie University, Canada (PHA4GE)
Jessica Boname
MRC, UK (JPIAMR, MRC)
Carolyn Johnson
MRC, UK (JPIAMR, MRC)
Workshop Resources and Recordings
All training materials from the AMR workshop are available below for researchers, educators, and practitioners seeking to revisit or reuse the content.
